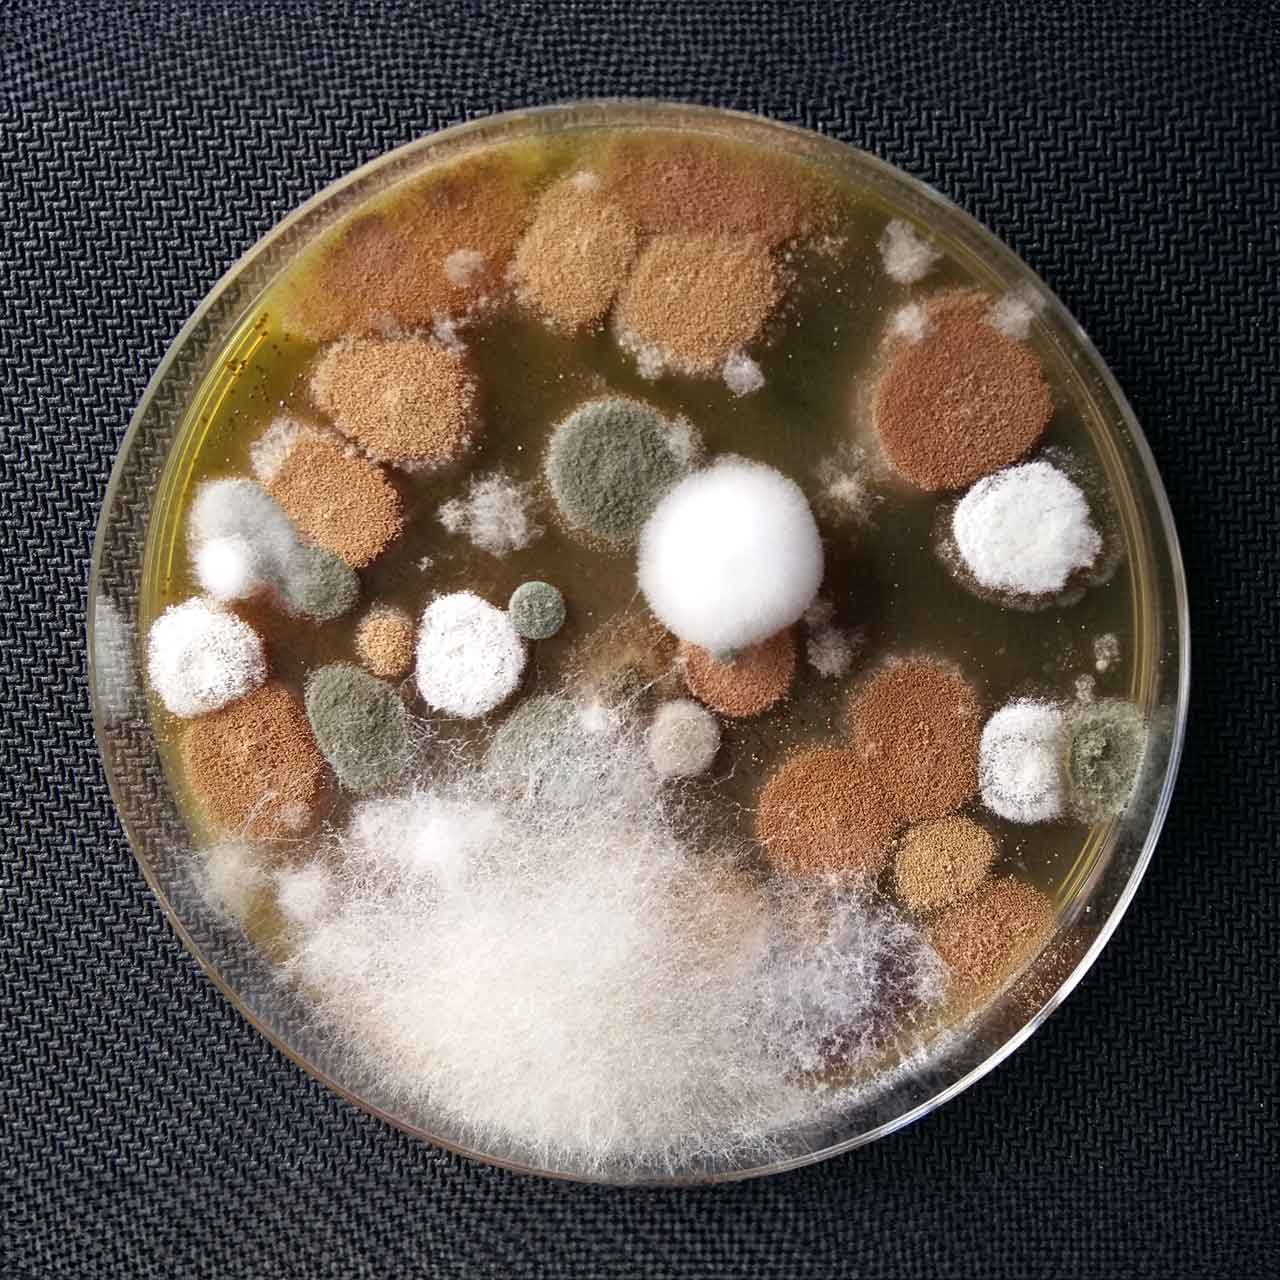
Laboratorio medioambiente
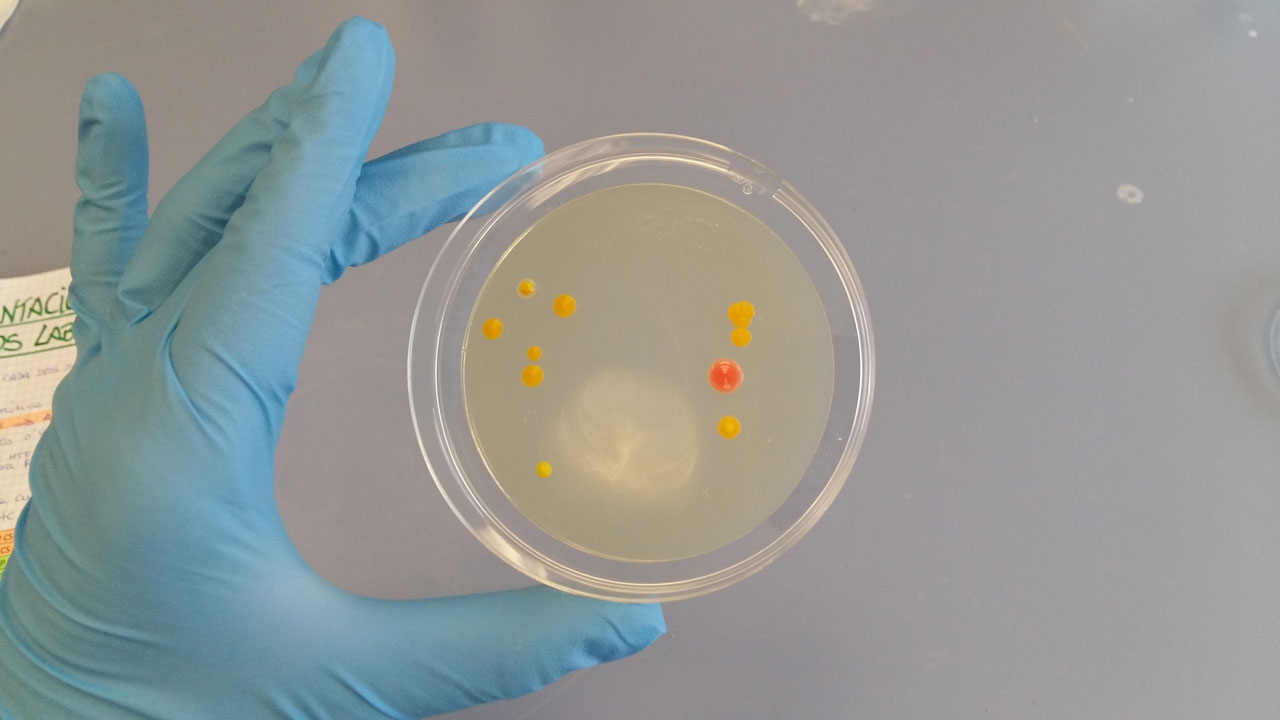

Medio Ambiente
Nuestro laboratorio biotecnológico apoya al departamento de consultoría y contribuye a mantener la intensa actividad de I+D+i desarrollada en la empresa.
Técnica consistente en medir la evolución microbiológica de un emplazamiento contaminado para, así, valorar la eficacia de un tratamiento de biorremediación y, en su caso, identificar potenciales acciones de mejora.
Recuento en placa
Actividad enzimática
ATPmetría
Respirometría

Técnica que permite determinar la cantidad y diversidad de bacterias, arqueas, hongos o algas (es decir, un grupo taxonómico concreto) en una muestra. Esto facilita conocer los microorganismos que intervienen en el proceso de descontaminación en proyectos de recuperación de suelos y aguas.

Técnica de precisión que cuantifica el ADN de una especie para:
- Verificar la presencia de un organismo clave en una ruta metabólica.
- Confirmar la ausencia de un patógeno que pueda afectar un proceso de descontaminación.
Algunas de las especies que cuantificamos:
- Patógenos: Pseudomonas aeruginosa, Escherichia coli, etc.
- Degradadoras de hidrocarburos
- Degradadoras de compuestos organoclorados: Dehalococcoides sp.
- Productoras de metano: Arqueas acetoclásticas

Aislamos y escalamos cultivos microbiológicos con el fin de acelerar la biorremediación de un emplazamiento. Para ello, KEPLER valora en cada caso concreto el uso de:
-
1.
Nuestra colección de consorcios microbiológicos
Reunida a lo largo de los años.
-
2.
Microorganismos del propio emplazamiento
Donde se ha producido la contaminación. Se toma una muestra de suelo de la cual se extrae y aísla la microbiota autóctona, que será concentrada y aclimatada previamente al contaminante.
Fases del Proceso

Identificación
Extracción y Aislamiento

Incubación a Escala Laboratorio

Escalado en Biorreactores

Técnica para evaluar la estrategia y viabilidad de las técnicas microbiológicas en un proyecto concreto a través de la identificación de posibles inhibidores sobre la microbiología derivados del producto contaminante o el emplazamiento.

Técnica para evaluar la toxicidad de un terreno o agua a través de la observación del crecimiento de cultivos u organismos de prueba (entre otros, lactuca sativa).